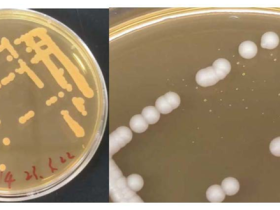
国家生猪技术创新中心在畜禽养殖舍净化 新技术开发方面取得重要进展

3月6—8日,中科院人力资源中心组织的“概念验证+中试熟化加快科技成果转化”高级研修班在广州顺利开班。国家生猪技术创新中心(以下简称国猪中心)选派3名来自成果转化与乡村振兴部的业务人员参加线下学习,数名科技成果转化相关工作者同步参加线上学习。
本次培训为期两天半,旨在帮助国内科研院所、高校及技术创新主体深入了解科技成果转化最新政策和模式经验、概念验证中心、中试平台与科技园区的管理体制、运营模式及实践成效等,更好更快地形成产业化,促进新质生产力的快速培育。培训内容涵盖科技成果转化最新政策及经典案例、概念验证中心运营管理体系、项目管理模式及实践等,并特邀中国科学院研究所、知名高校及行业专家授课,分享概念验证中心建设、科技成果评估、技术转移等成果和经验。
通过本次培训,学员们深入了解了“概念验证+中试熟化加快科技成果转化”的最新动态和发展趋势,并与其他学员进行沟通交流,为今后更好地开展科技成果转化工作开拓新思路。
国猪中心高度重视此次培训,将以此为契机,进一步加强中心科技成果转化工作,发挥概念验证、中试在创新链中的作用,为生猪产业高质量发展注入新的动力。